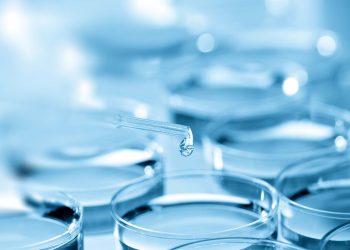

проведення тесту на COVID-19
Вартість ПЛР-тестування на коронавірус (COVID-19) становить 908 гр. та відповідає швидкості та якості проведення дослідження . Результат вже можна отримати через 4 години після здачі біоматеріалу.
наші перваги
Кваліфікований персонал
Роботу ЦПМ забезпечують 22 лікаря більшість з яких мають вищу кваліфікаційну категорію.
Сучасне обладнання
Лабораторія центру обладнана сучасним обладнанням, яке не має аналогів в Україні.
Унікальні методики
Лаборотароія Центру проводить дослідження по 700 унікальним методикам.
Доступне ціноутворення
Лабораторія Центру має оптимальне ціноутворення, завдяки багатолітньому досвіду та відлагодженому процесу.
Оптимальні сроки
Багаторічний досвід персоналу та новітнє обладнання дозволяє проводити дослідження у максимально стислі терміни.
Акредетовані за ISO 17025
Лабораторія Центру акредетована за міжнародним стандартом ISO 17025, що підкреслює фаховість та високі стандарти організації.
відгуки
Компанія AB Tetra Pak
Завжди приємно працювати з професіоналами. За багато років тісної співпраці – Центр Превентивної Медицини зарекомендував себе як надійний партнер.
Компанія Ашан
Центр Превентивної Медицини – має кваліфікований персонал та передове обладнання, що підтверджується бездоганною роботою завжди якісно та в строк.
Компанія Amway Україна
Співпраця з Центром Превентивної Медицини завжди залишає приємні враження. Високий рівень кваліфікації, та багаторічний досвід є підтвердженням цього.
Компанія Mary Kay
Багато років співпраці з Центром Превентивної Медицини, є основним критерієм оцінки. Відточений налагоджений процес та увага до деталей! Завжди вчасно та якісно.
новини
-
Коронавірусна інфекція COVID-19
Лютий 18, 2020 -
Грип та інші гострі респіраторні вірусні інфекції (ГРВІ)
Лютий 18, 2020 -
Продовжимо розмову про Стафілококи
Грудень 19, 2019 -
Шановні батьки, бабусі та дідусі!
Грудень 19, 2019
Якщо у вас є питання стосовно проведення досліджень, або вам потрібна консультація, зверніться до нас через форму зв’язку або зателефонуйте нам.
-
м.Київ, 03143, вул. Академіка Заболотного, 15
-
+38 044 526 51 11
-
-
м.Київ, 01220, вул. Банкова, 11
-
+38 (044) 255 73 33
-